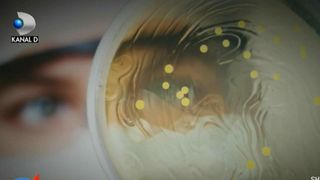

1 din 4 | Declarațiile uimitoare ale unui medic chirurg: Institutul Marius Nasta trebuie daramat si construit de la zero
2 din 4 | Declarațiile uimitoare ale unui medic chirurg: Institutul Marius Nasta trebuie daramat si construit de la zero
3 din 4 | Declarațiile uimitoare ale unui medic chirurg: Institutul Marius Nasta trebuie daramat si construit de la zero
4 din 4 | Declarațiile uimitoare ale unui medic chirurg: Institutul Marius Nasta trebuie daramat si construit de la zero
O spune un chirurg care opereaza aici, dupa ce trei oameni au murit din cauza unei bacterii periculoase. Ministerul Sanatatii a decis sa inchida blocul operator si sectia de terapie intensiva.
Toþi bolnavii care au nevoie urgentã de intervenþii chirurgicale vor fi transferaþi în alte spitale.
E strigatul disperat al unui doctor care a salvat pana acum sute de vieti si e nevoit sa opereze in conditii poate mai groaznice ca pe front.
Lipsurile din spitale, vechiul si mizeria impletesc un tablou care infioara. Si ucide. Imagini filmate recent cu o camera ascunsa dezvaluie dezastrul care domneste in spital.
Geamuri din lemn nevopsite si sparte, paturi vechi si rupte, saloane si toatele insalubre.
Un adevarat focar de infectie.
La Institutul Marius Nasta au murit pana acum trei pacienti cu boli grave, la care s-a confirmat si infectarea cu acinetobacter multirezistent.
Pentru alti doi bolnavi inca se asteapta rezultatele analizelor.
Oricum, doctorii spun ca niciunul n-ar fi luat bacteria din acest spital si ca nu aceasta infectie i-ar fi omorat.